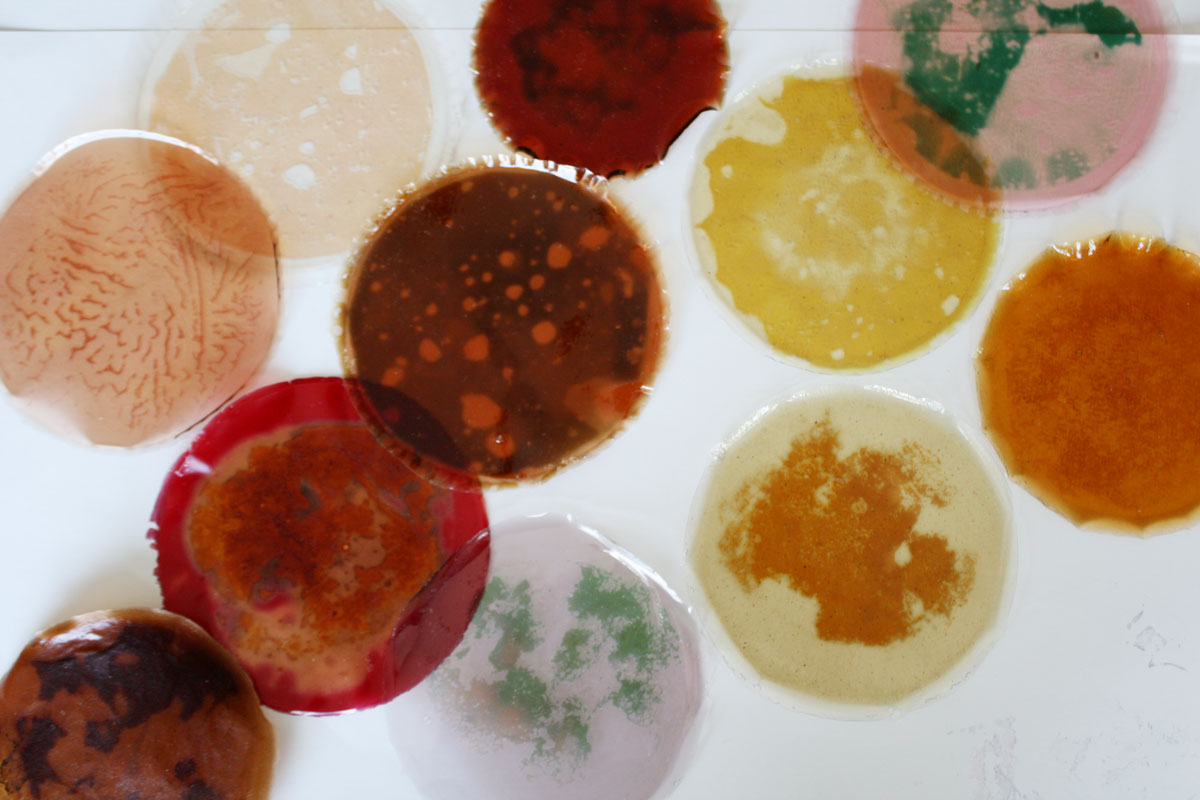

Portafolio biomaterial
Nace del interés por desarrollar materiales con y para la naturaleza. El proyecto de biodiseño busca experimentar con las paletas de colores que se pueden crear en cada uno de los materiales propuestos, mediante los tintes naturales. Todo lo anterior con el propósito de crear soluciones compostables que puedan llegar a sustituir los materiales existentes contaminantes en la industria de la moda.
- María Camacho Herrera Estudiante
- Electiva de Producto: BioModa Curso
-
Carolina Obregón Tarazona
Giovanna Danies Turano Profesores